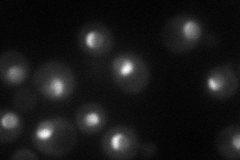
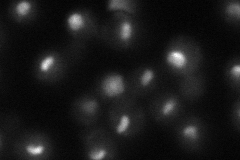
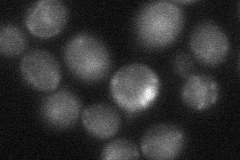

View description
Essential nucleolar protein involved in the early steps of 35S rRNA processing; interacts with Faf1p; member of a transcriptionally co-regulated set of genes called the RRB regulon
Localization:
Intensity:
Fold change:
Significance:
-
C’ GFP library in SD

nucleus46.78 -
N' NOP1pr-GFP in SD
nucleolus67.2975 -
N' TEF2pr-mCherry in SD

nucleus,nucleolus17.1718 -
N' NATIVEpr-GFP in SD
nucleus34.6518 -
N' TEF2pr-VC and Cyto-VN in SD
nucleus29.7589 -
C’ GFP library in SD+DTT

nucleus34.540.73No -
C’ GFP library in SD+H2O2

nucleusN/AN/ANo -
C’ GFP library in Starvation Media

punctateN/AN/AYes -
C’ GFP library on the background of Pup2-DaMP

nucleus -
C’ GFP library on the background of CCT mutant

nucleus43.75120.935031No
